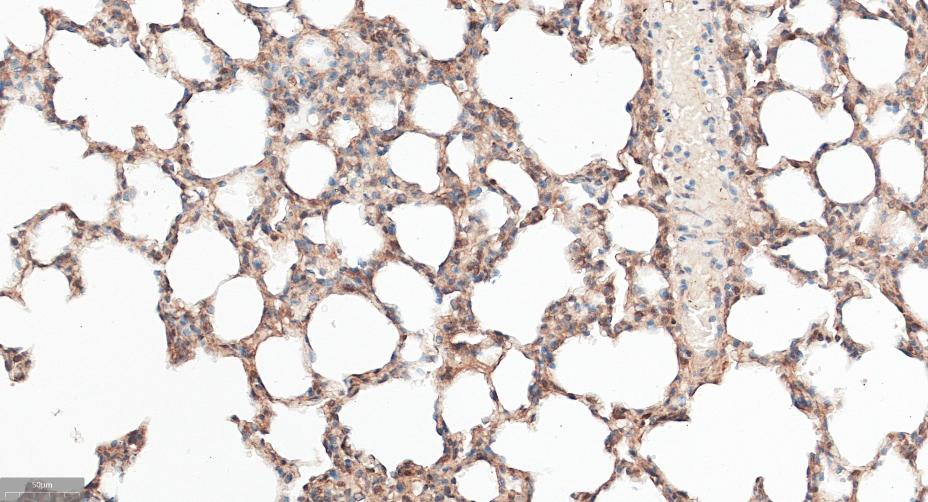
衔接因子蛋白含pH域蛋白1重组兔单抗

衔接因子蛋白含pH域蛋白1重组兔单抗
Rrmab?兔单抗

货号:bsm-61064R
产品详情
相关标记
相关产品
相关文献
常见问题
概述
产品编号
bsm-61064R
产品类型
重组兔单抗
英文名称
APPL1 Recombinant Rabbit mAb
中文名称
衔接因子蛋白含pH域蛋白1重组兔单抗
英文别名
APPL; DIP13alpha; MODY14; 2900057D21Rik; 7330406P05Rik; DIP13; RGD1309388; DP13A_HUMAN; APPL1; Dip13-alpha; Adapter protein containing PH domain, PTB domain and leucine zipper motif 1; DIP13A; KIAA1428; DP13A_MOUSE;
抗体来源
Rabbit
免疫原
A synthesized peptide derived from human Dip13 alpha: 400-450/709
性状
Liquid
纯化方法
affinity purified by Protein A
克隆类型
Recombinant
克隆号
6F1
理论分子量
80 kDa
浓度
1mg/ml
储存液
0.01M TBS(pH7.4) with 1% BSA, 0.02% Proclin300 and 50% Glycerol.
保存条件
Shipped at 4℃. Store at -20 °C for one year. Avoid repeated freeze/thaw cycles.
注意事项
This product as supplied is intended for research use only, not for use in human, therapeutic or diagnostic applications.
数据库链接
产品介绍
衔接因子蛋白含pH域磷酸酪氨酸结合域和亮氨酸拉链基元1抗体.
APPL1可调节脂联素和胰岛素信号,是细胞膜与细胞核之间重要的信息传递蛋白,同时也是细胞增殖所必需的蛋白,它有调节脂联素在脂肪酸氧化和葡萄糖吸收中的作用,APPL1通过激酶通道来调节脂联素的胰岛素敏感效应。
APPL1可调节脂联素和胰岛素信号,是细胞膜与细胞核之间重要的信息传递蛋白,同时也是细胞增殖所必需的蛋白,它有调节脂联素在脂肪酸氧化和葡萄糖吸收中的作用,APPL1通过激酶通道来调节脂联素的胰岛素敏感效应。
背景资料
The protein encoded by this gene has been shown to be involved in the regulation of cell proliferation, and in the crosstalk between the adiponectin signalling and insulin signalling pathways. The encoded protein binds many other proteins, including RAB5A, DCC, AKT2, PIK3CA, adiponectin receptors, and proteins of the NuRD/MeCP1 complex. This protein is found associated with endosomal membranes, but can be released by EGF and translocated to the nucleus. [provided by RefSeq, Jul 2008]

产品应用
| 应用 | 已检合格种属 | 预测种属 | 推荐稀释比例 |
|---|---|---|---|
| WB | Human, Mouse, Rat | 1:500-2000 | |
| IHC-P | Human, Mouse, Rat | 1:100-500 | |
| IHC-F | Human, Mouse, Rat | 1:100-500 | |
| IF | Human, Mouse, Rat | 1:100-500 |
交叉反应
交叉反应: Human, Mouse, Rat
相关产品
暂无相关产品
靶标
基因名
APPL1
蛋白名
DCC-interacting protein 13-alpha
亚基
Binds RAB5A/Rab5 through an N-terminal domain. This interaction is essential for its recruitment to endosomal membranes as well as its role in cell proliferation. Binds DCC and the catalytic domain of the inactive form of AKT2 through its PID domain. Binds PIK3CA and subunits of the NuRD/MeCP1 complex. Interacts with OCRL and INPP5B.
亚细胞定位
Early endosome membrane; Peripheral membrane protein. Nucleus. Note=Early endosomal membrane-bound and nuclear. Translocated into the nucleus upon release from endosomal membranes following internalization of EGF.
组织特异性
High levels in heart, ovary, pancreas and skeletal muscle.
翻译后修饰
Phosphorylated upon DNA damage, probably by ATM or ATR.
Phosophorylation at Ser-410 by PKA severely impairs binding to OCRL.
Phosophorylation at Ser-410 by PKA severely impairs binding to OCRL.
相似性
Contains 1 PH domain.
Contains 1 PID domain.
Contains 1 PID domain.
功能
Required for the regulation of cell proliferation in response to extracellular signals from an early endosomal compartment. Links Rab5 to nuclear signal transduction.
标记抗体
暂无标记数据
同靶标产品
暂无同靶标产品
相关文献
提示: 发表研究结果有使用 bsm-61064R 时请让我们知道,以便我们可以引用参考文章。作为回馈,资料提供者将获得我们送上的小礼品。
暂无相关文献
常见问题
暂无常见问题